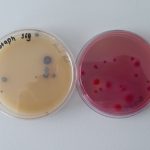

साउन २२, काठमाडौं ।
कृषि तथा पशुपन्छी विकास मन्त्री चक्रपाणी खनाल ‘बलदेव’ले जनस्वास्थ्यमा खेलवाड गर्ने जोसुकैलाई पनि तत्काल रेड कार्ड दिन खाद्य प्रविधि तथा गुण नियन्त्रण विभागलाई निर्देशन दिएका छन् । विभागको तेस्रो चौमासिक प्रगति समिक्षा बैठकमा मन्त्री खनालले जनस्वास्थ्यमा खेलवाड गर्ने छुट कसैलाई नभएको भन्दै त्यही अनुसार कडा कदम चाल्न विभागलाई निर्देशन दिए ।
मातहतका संयन्त्र राम्रोसँग चलेनन् भने परिणाम ननिस्कने भन्दै मन्त्री खनालले आफूसँग भएको सम्पूर्ण संयन्त्र परिचालन गर्न निर्देशन दिए । विभागको ठूलो दायित्व रहेको भन्दै खनालले अहिले त्यो पूरा हुन नसकेकोमा असन्तुष्टि जनाए । ‘विभागको निक्कै ठूलो जिम्मेवारी छ, अहिले त्यो पूरा भएको छैन, मन्त्री खनालले भने, अन्तराष्ट्रिय प्रतिष्पर्धामा हामीले गर्ने काम पुग्दो छ कि छैन ? तपाईहरु आ–आफ्ना छोराछोरी सम्झेर काम गर्नुस्, समिक्षा आफै गर्नुस् ।’
जनस्तरबाट उठेका प्रश्नको जवाफ विभागले दिनु पर्ने उनको भनाई छ । आफ्नो घेरा भित्र रहेर हरेक ठाउँमा अनुगमन र चेकजाँच गर्नुस्, खनालले भने, ‘साथ दिने म छु, हरेक ठाउँमा निर्देशनको मात्र भर पर्न पर्दैन ।’ पटक पटक अनुगमन र चेकजाँच गर्ने, नमूना फरक फरक ढंगले संकलन गर्न निर्देशन दिँदै मन्त्री खनालले राम्रो गर्ने उद्योगलाई पुरस्कृत र प्रचार तथा नराम्रोलाई कार्वाहीको दायरामा ल्याउनु पर्ने बताए ।
पानी, दुध र मुख्य खाद्य बस्तुमा सकृया भएर लाग्न आग्रह गर्दै खनालले ६ महिनापछि फेरी समिक्षा गर्ने बताए । ‘ल्याव बिग्रेको छ भने बिग्रेको भन्नुस्, बजेट र जनशक्ति छैन भने त्यो जानकारी गराउनुस्, सबै छ गर्न सकिएन भने त्यो पनि भन्नुस्, खनालले भने, ‘अनि के गर्नुपर्छ म गर्छु, कोहीसँग कोही गरााउनु पर्दैन ।’ राम्रो शुरुवात नभए केहीको पनि गणना नहुने उनको भनाई थियो ।
कार्यक्रममा विभागका महानिर्देशक सञ्जिवकुमार कर्णले मन्त्रीले भनेका कुराहरुलाई आफ्नो दायित्व सम्झेर काम गर्ने प्रतिवद्धता जनाए । पटक पटक अनुगमन गरेर सुधार गर्न निर्देशन दिँदा पनि सुधार नगर्ने उद्योग बन्द गराउने उनको भनाई थियो । विभागले अनुगमनलाई तिब्र बनाएको तर स्रोत साधार र जनशक्ति प्रयाप्त नरहेको महानिर्देशक कर्णको भनाई थियो ।
विभागका अनुसार गत आर्थिक वर्षमा देशभरीबाट २ हजार ८ सय १३ वटा नमूना संकलन गरी परिक्षण गर्द ३ सय ५४ वटा न्यून गुणस्तरका पाइएको छ । त्यसमध्ये खाद्य समूहमा सबैभन्दा बढी १४० वटा न्यून गुणस्तरको पाइएको छ । जसमध्ये दुध तथा दुग्ध पदार्थ ७२, प्रसोधित पिउने पानी २६, गुलियो पदार्थ १७, तेल तथा घ्युजन्य पदार्थ ११ वटा न्यून गुणस्तरको पाइएको विभागका वरिष्ठ खाद्य अनुसन्धान अधिकृत नवराज दाहालले जानकारी दिए ।
केयर फाउणडेशन द्वारा संचालित:
तपाईंको प्रतिकृयाहरू